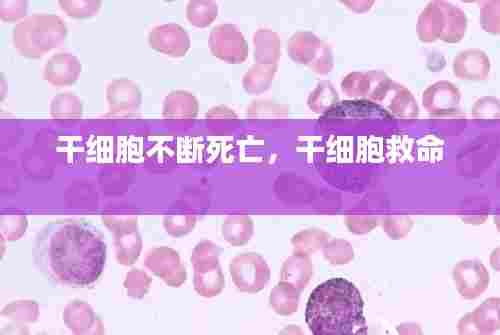
干细胞不断死亡，干细胞救命

龙岩莲塘小区深度揭秘,居住环境、配套设施一网打尽
龙岩莲塘小区作为龙岩市的一个重要社区,近年来在城市建设和发展中扮演着日益重要的角色,本文将围绕莲塘小区的地理位置、历史背景、配套设施、居民生活以及未来发展等方面展开专题探讨,以期为读者提供一个全面的视角,深入了解这个...
揭秘养鸡行业,哪些人群最适合养鸡赚钱?百度收录标题推荐
随着农村经济的发展和农业产业结构的调整,养殖业逐渐成为了农民增收的热门行业之一,养鸡作为一种投资小、见效快的养殖项目,备受广大农户的青睐,百度一下,哪些人适合养鸡呢?热爱农业、愿意投入时间精力的人适合养鸡的人一定是热...
南和区火灾事件惊险实录,现场直击与反思
在一个平静的午后,南和区突发了一起火灾事件,给当地带来了不小的震动,火灾的突然发生,不仅考验着当地应急部门的反应能力,也牵动着无数居民的心弦。火灾突发南和区,一个宁静的午后,阳光洒在街道上,人们各自忙碌着生活琐事,一...
突发氧气综合症,缺氧时突发的临床表现是
什么是突发氧气综合症突发氧气综合症,又称为氧气中毒或高压氧中毒,是一种由于吸入高浓度氧气引起的急性生理和病理变化。这种症状通常发生在潜水员、高空飞行员、高压氧舱治疗患者以及某些特殊环境下的工作者中。当人体吸入的氧气...
突发任务冰雾花,冰雾花怎么获得
任务降临:冰雾花的神秘使命在一个普通的冬日午后,城市的喧嚣被一片突如其来的宁静所取代。天空中的阳光透过薄薄的云层,洒在繁忙的街道上,一切都显得那么平静。然而,在这平静的外表下,一场不平凡的挑战正在酝酿。就在这时,一...
干细胞不断死亡,干细胞救命
引言:干细胞——生命的源泉干细胞,作为生物体内具有自我更新和多向分化潜能的特殊细胞,是维持组织和器官功能的关键。它们存在于多种组织和器官中,如骨髓、脂肪、皮肤等,扮演着修复损伤、再生组织的重要角色。然而,随着科学研...
十大考研热门专业排行,考研十大热门院校
引言随着社会的发展和就业市场的变化,考研成为了越来越多大学生的选择。为了帮助考生更好地了解考研趋势,本文将为您盘点2023年考研十大热门专业排行,供您参考。1. 金融学金融学专业一直是考研的热门专业之一。随着金...
24款皓影门边,皓影有车门灯吗
皓影门边的独特设计理念在汽车设计中,门边往往是一个容易被忽视的细节,但24款皓影门边的设计却展现出了独特的匠心独运。这款车型在设计之初,就秉承了“细节决定成败”的理念,将门边作为提升整体质感的关键环节。精湛的工艺...
夏天热门口红色,适合夏天的口红色
夏天热门口红色调的流行趋势随着夏天的脚步渐近,各大时尚品牌纷纷推出了夏季新品,其中,口红色调成为了热门话题。在这个炎热的季节,选择一款适合的口红不仅能够提升气质,还能为你的夏日造型增添一抹亮色。红色调的分类与特点...
崂山火灾实时情况视频,崂山区火灾
火灾发生背景近日,山东省青岛市崂山区发生了一起严重的森林火灾。根据初步了解,火灾于2023年某月某日早晨6点左右在崂山区某森林公园内突然爆发。火灾发生时,正值高温干燥季节,火势迅速蔓延,给当地居民的生命财产安全带来...

琼ICP备2024026137号-1
琼ICP备2024026137号-1